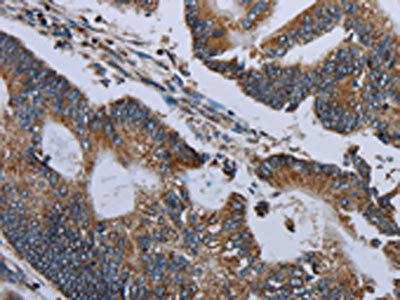

NDUFA13 Antibody
-
中文名稱:NDUFA13兔多克隆抗體
-
貨號(hào):CSB-PA161916
-
規(guī)格:¥1100
-
圖片:
-
The image on the left is immunohistochemistry of paraffin-embedded Human ovarian cancer tissue using CSB-PA161916(NDUFA13 Antibody) at dilution 1/50, on the right is treated with fusion protein. (Original magnification: ×200)
-
The image on the left is immunohistochemistry of paraffin-embedded Human colon cancer tissue using CSB-PA161916(NDUFA13 Antibody) at dilution 1/50, on the right is treated with fusion protein. (Original magnification: ×200)
-
Gel: 10%SDS-PAGE, Lysate: 40 μg, Lane 1-2: Mouse skeletal muscle, human hepatocellular carcinoma tissue, Primary antibody: CSB-PA161916(NDUFA13 Antibody) at dilution 1/350, Secondary antibody: Goat anti rabbit IgG at 1/8000 dilution, Exposure time: 5 minutes
-
-
其他:
產(chǎn)品詳情
-
Uniprot No.:
-
基因名:
-
別名:NDUFA13; GRIM19; CDA016; CGI-39; NADH dehydrogenase [ubiquinone] 1 alpha subcomplex subunit 13; Cell death regulatory protein GRIM-19; Complex I-B16.6; CI-B16.6; Gene associated with retinoic and interferon-induced mortality 19 protein; GRIM-19; Gene associated with retinoic and IFN-induced mortality 19 protein; NADH-ubiquinone oxidoreductase B16.6 subunit
-
宿主:Rabbit
-
反應(yīng)種屬:Human,Mouse
-
免疫原:Fusion protein of Human NDUFA13
-
免疫原種屬:Homo sapiens (Human)
-
標(biāo)記方式:Non-conjugated
-
抗體亞型:IgG
-
純化方式:Antigen affinity purification
-
濃度:It differs from different batches. Please contact us to confirm it.
-
保存緩沖液:-20°C, pH7.4 PBS, 0.05% NaN3, 40% Glycerol
-
產(chǎn)品提供形式:Liquid
-
應(yīng)用范圍:ELISA,WB,IHC
-
推薦稀釋比:
Application Recommended Dilution ELISA 1:2000-1:5000 WB 1:500-1:2000 IHC 1:100-1:300 -
Protocols:
-
儲(chǔ)存條件:Upon receipt, store at -20°C or -80°C. Avoid repeated freeze.
-
貨期:Basically, we can dispatch the products out in 1-3 working days after receiving your orders. Delivery time maybe differs from different purchasing way or location, please kindly consult your local distributors for specific delivery time.
-
用途:For Research Use Only. Not for use in diagnostic or therapeutic procedures.
相關(guān)產(chǎn)品
靶點(diǎn)詳情
-
功能:Accessory subunit of the mitochondrial membrane respiratory chain NADH dehydrogenase (Complex I), that is believed not to be involved in catalysis. Complex I functions in the transfer of electrons from NADH to the respiratory chain. The immediate electron acceptor for the enzyme is believed to be ubiquinone. Involved in the interferon/all-trans-retinoic acid (IFN/RA) induced cell death. This apoptotic activity is inhibited by interaction with viral IRF1. Prevents the transactivation of STAT3 target genes. May play a role in CARD15-mediated innate mucosal responses and serve to regulate intestinal epithelial cell responses to microbes.
-
基因功能參考文獻(xiàn):
- These results indicated that rAd-Grim-19 may regulate tumor cell growth and apoptosis. Additionally, the results demonstrated that rAdGrim19 led to beneficial outcomes and prolonged the survival of esophageal tumorbearing mice. In conclusion, the present study demonstrated that rAdGrim19 may have potential as an antitumor agent for esophageal neoplasms PMID: 29488605
- Low GRIM19 expression is associated with radiation resistance in osteosarcoma. PMID: 30005830
- GRIM-19 is a potential predictor of prognosis and disease recurrence in high grade serous carcinoma PMID: 29254797
- Promoting the expression of GRIM19 may yield therapeutic benefits in the treatment of RA. PMID: 29306209
- MiR-6743-5p may act as an oncomiRNA in glioma by targetting GRIM-19 and STAT3. PMID: 29074558
- GRIM-19 suppresses the proliferation and invasion of cutaneous squamous cell carcinoma cells associated with downregulation of STAT3 signaling. PMID: 28926927
- Mitochondrial GRIM-19 could not only serve as an valuable prognostic biomarker for gastric cancer development, but also as a potential therapeutic target for STAT3-dependent carcinogenesis of Gastric cancer. PMID: 27167343
- GRIM-19 expression in cervical cancer cells could inhibit telomerase activity by inhibiting the transactivation of the hTERT promoter by E6, thereby promoting cervical cancer cell senescence. PMID: 27142689
- NDUFA13 deficiency may be associated with asthenozoospermia through the disturbance of spermatozoa mitochondrial membrane potential and by increasing apoptosis and intracellular reactive oxygen species PMID: 27789183
- GRIM-19 overexpression suppressed hepatocellular carcinoma (HCC) growth and downregulated AKT1 expression, suggesting that GRIM-19 might play a crucial role in hepatocarcinogenesis through negatively regulating the PI3K/AKT signaling pathway. PMID: 25550785
- Low GRIM-19 expression is associated with paclitaxel resistance in cervical cancer. PMID: 26810068
- activation of AMPKalpha by metformin was associated with a reversal of the suppressed GRIM-19 expression in H9C2 cells, the fold of changes in GRIM-19 expression by metformin were much less in HeLa cells PMID: 27101310
- Data suggest that tumor expression of Ki67 (antigen Ki-67) and GRIM19 correlate with malignancy in thyroid Hurthle cell (HC) tumors; variable expression of Ki67 and GRIM19 may helped differentiate HC carcinoma from HC adenoma. PMID: 26188382
- Transfection with eukaryotic plasmid for the simultaneous expression of GRIM19 and LKB1 more effectively suppressed the growth of breast cancer in vitro and in vivo, and may therefore have therapeutic potential for the treatment of human breast cancer. PMID: 26458553
- Aberrant endometrial expression of GRIM-19 was associated with adenomyosis through the regulation of apoptosis and angiogenesis. PMID: 26769301
- We established here a correlation between the first mutation identified in the NDUFA13 gene, which induces Mitochondrial complex I instability and a severe but slowly evolving clinical presentation affecting the central nervous system. PMID: 25901006
- Upregulation of GRIM-19 also suppressed the secretion of urokinase-type plasminogen activator (u-PA), matrix metalloproteinase (MMP)-2, MMP-9 and vascular endothelial growth factor (VEGF). PMID: 25955394
- GRIM-19 expression is closely associated with colorectal cancer progression and might be a very promising prognostic biomarker PMID: 26363526
- Upregulation of GRIM-19 in oral squamous cell carcinoma cells significantly inhibited cell proliferation, migration and invasion in vitro and suppressed tumor growth in vivo. PMID: 25174621
- decreased GRIM-19 expression due to promoter hypermethylation may be important in head and neck carcinogenesis by promoting cell proliferation and regulating metabolic activity PMID: 25575809
- Simultaneous expression of ADAM10-specific siRNA and GRIM19 in HepG2 cancer cells significantly inhibited the proliferation, migration and invasion. PMID: 25242535
- The GRIM-19 deficiency in the villus may be associated with missed abortion via increasing apoptosis and affecting angiogenesis. PMID: 25455534
- GRIM-19 may regulate the differentiation of normal cervical tissue, and a decrease in GRIM-19 may be the result of HR-HPV infection, which in turn leads to the malignant transformation of the cells. PMID: 24690422
- GRIM-19 mutations are associated with oral squamous cell carcinoma. PMID: 23851499
- role in macrophage apoptosis induced by H5N1 virus PMID: 23529854
- silencing of survivin and over-expression of GRIM-19 can significantly inhibit the growth and induce the apoptosis of Hep-2 laryngeal cancer cells in vitro and in vivo. PMID: 24133585
- Downregulation of GRIM-19 promotes HIF1alpha synthesis. PMID: 23580587
- Expressions of GRIM-19, NDUFS3, and extracellular matrix elements are correlated with invasive capabilities of breast cancer cell lines. PMID: 23630608
- Down-regulation of GRIM-19 is associated with STAT3 overexpression in breast carcinomas. PMID: 23618357
- GRIM-19 expression is closely correlated with histological grading and p-STAT3 in hepatocellular carcinoma PMID: 22492280
- Our study found that GRIM-19 expression in lung cancer exhibits a relationship with the histological type and clinical stage PMID: 22573109
- Tumor-derived mutations in the gene associated with retinoid interferon-induced mortality (GRIM-19) disrupt its anti-signal transducer and activator of transcription 3 (STAT3) activity and promote oncogenesis PMID: 23386605
- import of the transcription factor STAT3 into mitochondria depends on GRIM-19, a component of the electron transport chain PMID: 23271731
- GRIM-19 inhibits the STAT3 signaling pathway and sensitizes gastric cancer cells to radiation. PMID: 23124042
- GRIM-19 plays a critical role not only at the origin but also in the invasive progression of hepatocellular carcinoma. PMID: 22105514
- GRIM-19 expression was lower in gliomas & negatively correlated with malignancy. Downregulation enhanced cell proliferation & migration, but overexpression did the opposite. GRIM-19 exerts its role through the non-STAT3 signaling pathway. PMID: 21827581
- GRIM-19 function in cancer development PMID: 21664299
- The expressions of survivin and GRIM-19 may be closely correlated with the pathogenesis of prostate cancer. PMID: 21351527
- These data suggest that GRIM-19 can block E6/E6AP complex; and synergistically suppress cervical tumor growth with p53. PMID: 21765936
- reduced mRNA and protein levels in lung adenocarcinoma tissues PMID: 21040996
- GRIM-19 expression is down-regulated in non-small cell lung cancer. PMID: 19622307
- Results identify a major role for the N terminus of GRIM-19 in mediating its tumor-suppressive actions. PMID: 20595633
- Alternatively spliced GRIM-19 mRNA is associated with kidney cancer. PMID: 20505682
- GRIM-19/CDKN2A synergistically suppressed cell cycle progression via inhibiting E2F1-driven gene expression. PMID: 20522552
- Loss of GRIM-19 is associated with invasion and metastasis of human gastric cancer. PMID: 20478305
- Data show that restoration of GRIM-19 levels reestablishes the control over STAT3-dependent gene expression and tumor growth in vivo. PMID: 19642906
- results collectively indicate that viral interferon regulatory factor 1 modulates interferon/retinoic acid-cell death signals via interactions with GRIM19 PMID: 12163600
- GRIM-19 is an inhibitor of signal transducer and activator of transcription 3 PMID: 12867595
- GRIM-19 may be a key component in NOD2-mediated innate mucosal responses and serve to regulate intestinal epithelial cell responses to microbes PMID: 15753091
- The IFN-beta- and tretinoin-induced GRIM-19 is upregulated during focal cerebral ischemia. PMID: 17523870
顯示更多
收起更多
-
相關(guān)疾病:Hurthle cell thyroid carcinoma (HCTC)
-
亞細(xì)胞定位:Mitochondrion inner membrane; Single-pass membrane protein; Matrix side. Nucleus.
-
蛋白家族:Complex I NDUFA13 subunit family
-
組織特異性:Widely expressed, with highest expression in heart, skeletal muscle, liver, kidney and placenta. In intestinal mucosa, down-regulated in areas involved in Crohn disease and ulcerative colitis.
-
數(shù)據(jù)庫(kù)鏈接:
Most popular with customers
-
-
YWHAB Recombinant Monoclonal Antibody
Applications: ELISA, WB, IHC, IF, FC
Species Reactivity: Human, Mouse, Rat
-
Phospho-YAP1 (S127) Recombinant Monoclonal Antibody
Applications: ELISA, WB, IHC
Species Reactivity: Human
-
-
-
-
-